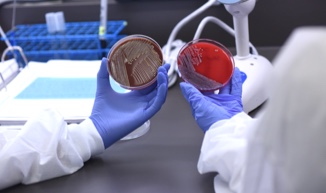
programs_labsciences_card1

Our Healthcare Programs and Pathways
On-Campus and Online Degrees & Certifications
At Carolinas College, we make it easy to pursue the right path for you. No matter which path you choose, each program is designed to expand minds and open possibilities. Our small school and one-on-one faculty support give students access to world-class hospital opportunities at Atrium Health, enabling graduates to consistently achieve licensure and certification pass rates well above state and national norms. Keep aiming high – we’ll help you get there.
Connect With Us and Get Your Exclusive Admissions Guide
Want to learn more? Fill out the form and we'll connect with you soon. Plus, get a helpful admissions guide full of great info.
Clinical Laboratory Sciences
-
Medical Laboratory Science
Certificate
Learn all the skills you'll need to analyze samples in the lab. For those who already have a bachelor's degree. -

Medical Laboratory Science (MLT - MLS)
Certificate
Learn all the skills you'll need to analyze samples in the lab. For those who already have a bachelor's degree. -

Histotechnology
Certificate
This in-demand field is all about analyzing tissues in order to treat diseases. -

Phlebotomy
Non-Credit Certificate
Learn the basics of collecting blood specimens and become a behind-the-scenes hero of laboratory science. -

Specialist in Blood Bank Technology
Non-Credit Certificate
For blood bank technologists who are looking to advance their careers and become specialists in the blood center and transfusion medicine fields.
Diagnostic and Imaging Sciences
-
-

Neurodiagnostic Technology
Associate Degree or Certificate
For students who love to solve complex problems. NDT is all about treating brain diseases. -

Radiologic Technology
Associate Degree
Part science and part art. This program is focused on using X-rays to perform diagnostic imaging. -

Medical Dosimetry
Certificate
Utilize critical analysis to develop radiation therapy treatment plans. For those certified in radiation therapy. -

Radiation Therapy
Certificate
Learn to use technology for research and the treatment of cancer. For those certified in radiologic technology or nuclear medicine. -

CT (Computed Tomography)
Non-Degree Course
For the radiographer looking to build skills in advanced CT procedures. May be used as professional development or to meet education requirements for certification exams. -

Mammography
Non-Degree Course
For the radiographer looking to build skills in the diagnosis and screening for breast cancer. May be used as professional development or to meet education requirements for certification exams. -

MRI (Magnetic Resonance Imaging)
Non-Degree Course
For the radiographer looking to build skills in MRI procedures. May be used as professional development or to meet education requirements for certification exams.
Health Sciences and General Education
-

Health Sciences
Bachelor's Degree
Start your career in healthcare or build upon an existing degree or coursework with a bachelor’s degree in health sciences. Concentration options include Simulation or Leadership. -

General Studies
Associate Degree
Coursework that builds a solid foundation for your healthcare career. -

Healthcare Simulation
Certificate
This unique and emerging field combines education, technology, operations, research and leadership skills. -

Project Management
Non-Degree Course
For the professional looking to gain an understanding of project management. May be used as professional development or to meet education requirements for certification exams.
Nursing
Please visit our FAQ page for frequently asked questions about the programs offered at Carolinas College.

Not sure where to start?
Let us give you the one-one-one attention you deserve. Contact our Admissions team today for a quick and easy consultation.
Admissions@CarolinasCollege.edu
704-355-5051




